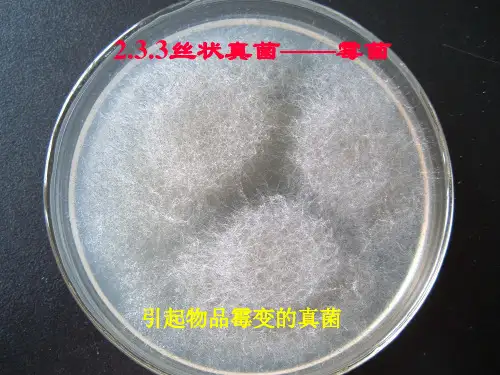

食品中常见霉菌及其生物特性.
- 格式:ppt
- 大小:2.27 MB
- 文档页数:43



食品中霉菌和酵母分布、检测和鉴定福建省疾病预防控制中心马群飞1. 霉菌和酵母的基本特性霉菌和酵母这种称谓仅是为了方便起见,将小型真菌有真正菌丝的称为霉菌,没有菌丝的称酵母,并没有分类学上的依据。
相对于低等的细菌来说,霉菌和酵母生长缓慢,竞争能力较弱,故霉菌和酵母常在不利于细菌生长繁殖的环境中形成优势菌群。
由于霉菌和酵母的细胞较大,新陈代谢能力强,故102~104个酵母即可引起一克食物的变质,而细菌则需要100倍于此数的细胞。
通常霉菌和酵母适合在高碳低氮有机物如植物性物质上生存。
适合的pH 3~8,有些霉菌可以在pH2,酵母在pH 1.5时生活。
水活度要求0.99~0.61,霉菌0.85时最适宜,某些嗜渗酵母和霉菌常引起糖果类食品的变质。
一般的霉菌的生长温度为20~30℃,部分霉菌可以在不低于-7℃的温度下生长。
酵母一般在0~45℃时生长。
耐热能力较差,酵母细胞55~56℃几分钟就被杀死。
少数霉菌的孢子(如丝衣霉)则可在90℃中耐受几分钟。
霉菌和酵母很多可以耐受防腐剂。
如乳酸、醋酸、CO2和SO2等。
有些酵母酯酶活性高并能合成B族维生素。
2. 食品中酵母的常见类群在食品中能分离出各种酵母菌,但它们很可能没有什么意义,因为其中多数来源于外界的偶然污染。
仅有非常有限的几个酵母属可使经过加工并正常生产工艺包装的食品腐败。
比如抗SO2熏蒸的酵母,就是饮料、葡萄酒变质的常见因素。
耐受保鲜剂的毕赤酵母,高度嗜氧,可以形成泡菜和酱油的表面膜。
当然,如果不按照标准的生产程序进行食品生产,那么许多外界污染的酵母都将在食品中大量繁殖,这种情况下,就谈不上优势菌群问题了,也不必进行酵母的分类鉴定。
处理方法只有一个,恢复正常的生产程序。
2.1 乳制品:鲜奶易因细菌污染而腐败,酵母菌不是重要问题。
当鲜奶被加工成奶油、乳酪、酸奶等制品后,由于细菌被抑制,酵母可相应地成为优势菌。
它们使奶油、乳酪产生怪味和气体,使黄油产生有味物质,并可使酸奶和酸乳酪腐败。


霉菌的基本结构及其在食品中的作用霉菌是一种单细胞或多细胞的真菌,它们通常可以在不同环境下生长和繁殖。
霉菌的基本结构主要包括菌体、菌丝、孢子等,这些结构决定了霉菌在食品中的生长方式和作用。
菌体是霉菌的主要结构,一般呈圆柱形或长圆形,表面有许多皱褶。
霉菌的菌体内部包含细胞核、质体、线粒体等细胞器,这些细胞器共同协作完成霉菌的生命活动。
菌丝是霉菌的另一个重要结构,是由菌体分化出来的长而细的丝状物,是霉菌的生物量主体。
菌丝从菌体中伸出,互相纵横交错,形成了一个复杂的菌丝网,这样的构造可以帮助霉菌对食材进行充分利用。
孢子是霉菌的繁殖体,可以从霉菌的菌丝、菌体或在其他地方形成,与细菌不同,霉菌的孢子可以在干燥的环境中保持较长时间的活力。
那么,霉菌在食品中有着怎样的作用呢?首先,霉菌可以帮助食材变质。
霉菌特别喜欢生长在潮湿、温暖又空气流通的环境中,一旦食材受潮或受到气流污染,就可能让霉菌繁殖和生长。
霉菌会分泌出各种异味,改变食材的口感和储存特性。
其次,霉菌可以制作成不同味道的食品。
在许多国家的饮食文化中,霉菌是常见的调味料。
例如,在蓝纹奶酪、酸奶、豆腐乳等食品中,都含有不同种类的霉菌。
它们作为自发的菌落,可以使食品发酵,产生并放大各种味道和风味物质。
霉菌还可以被用来制作酱油、味噌、蕨菜凉粉、豆腐等传统食品,这些食品的口感和味道都有极大的区别于其他制品,得到了广泛的认可。
此外,霉菌还可以制作药品。
一些含有霉菌发酵物的药品,例如青霉素和链霉素,是对许多常见细菌感染极为有效的抗生素。
不过,需要注意的是,霉菌不一定总是有益的。
在某些情况下,霉菌在食品中繁殖会对人体健康造成不良影响,例如霉变花生、霉变玉米饲料等,存放不当可能导致人和动物中毒。
综上所述,霉菌作为一种广泛存在于自然界中的生物,在食品、医药、科学等方面都有着十分广泛的应用。
了解霉菌的基本结构以及它在食品中的作用,可以使我们更好地掌握买菜、烹饪和储存的方法,并更加明智地选择食品和药品。

食品中常见的微生物第一篇:常见食品中的细菌细菌是一类单细胞微生物,它们广泛存在于土壤、水体、空气、食品等环境中。
在食品中,细菌不仅会引起食品变质,还会引起食品中毒。
本文将介绍常见食品中的细菌。
1. 大肠杆菌大肠杆菌是一类重要的肠道细菌,它们广泛存在于人和动物的肠道中,也能存在于水和土壤中。
尽管大多数大肠杆菌对人体无害,但也有一些菌株会引起食物中毒。
食品中的大肠杆菌主要来源于粪便,它们会通过肉类、蔬菜等食品污染到人类食品链中。
食品中的大肠杆菌可引起腹泻、呕吐、腹痛等症状。
2. 沙门氏菌沙门氏菌是一类常见的食品中毒致病菌,它们广泛存在于病畜、家禽、爬行动物等动物体内。
沙门氏菌能够在环境中存活多年,而且能够在低温下生长。
食品中的沙门氏菌主要来源于生鲜食品,如鸡蛋、家禽、猪肉等。
食品中的沙门氏菌可引起腹泻、发热、恶心、呕吐等症状。
3. 金黄色葡萄球菌金黄色葡萄球菌是一种常见的细菌,它们广泛存在于自然环境中。
金黄色葡萄球菌在人类和动物的皮肤上均有存在,但不会引起疾病。
食品中的金黄色葡萄球菌主要来源于肉类、乳制品等食品,因为它们可以在低温下繁殖,而且不易被加热杀灭。
食品中的金黄色葡萄球菌可引起腹泻、恶心、呕吐、发热等症状。
4. 嗜酸乳杆菌嗜酸乳杆菌是一类常见的食品中的有益菌,它们广泛存在于酸奶、酸乳饮品、奶酪等乳制品中。
嗜酸乳杆菌有助于消化和吸收食物,增强人体免疫力,对防治肠道疾病有一定作用。
5. 乳酸菌乳酸菌是一类常见的食品中的有益菌,它们广泛存在于酸奶、奶酪、醋栗酒、泡菜等食品中。
乳酸菌有助于维持肠道微生物平衡,促进食物消化吸收,对防治腹泻、便秘等疾病有一定作用。
总的来说,食品中的细菌是广泛存在的,对人体健康有着重要的影响,因此我们在食用食品时要注意卫生,尽量避免过多接触细菌,以免引起食物中毒。
第二篇:常见食品中的真菌真菌是一类微生物,广泛存在于自然环境中。
在食品中,真菌常常会造成食品变质,导致人们食用不安全的食品,因此对于食品中的真菌应保持一定的关注。

食品工厂常见霉菌及其特征一、常见霉菌1.曲霉在自然界中分布广泛, 它以土壤或空气为媒介, 而污染至食品原料。
该霉在原料贮藏期间几乎不会死亡。
因其对干燥抗性强, 故常在一些干燥食品中被分离出来, 而糖类和壳类处理工厂, 也常被此类霉菌污染。
曲霉会产生黄曲毒素, 为天然致癌物质中致癌性最强的霉菌毒素。
2.青霉与曲霉一样在自然界中广泛分布, 而且具同样的生态, 但曲霉生长于中温至高温, 而青霉以中温性为主, 青霉也是以土壤和空气为媒介, 而污染至食品原料中, 是干燥性壳物产品处理工厂的主要霉菌。
其有害性是造成食品腐败和产生霉菌毒素以及诱发过敏。
3.毛霉毛霉在土壤、粪便、禾草及空气等环境中存在。
在高温、高湿度以及通风不良的条件下生长良好。
在工厂湿度高的环境、通风不良的环境与气温差异显著的地方(如湿的地板和天花板) , 常有此霉菌存在。
4.交链孢霉属中温性和好湿性霉菌。
其有害性是造成腐朽、腐败和过敏。
在高湿度的工厂环境(如鱼肉、水产加工与肉食加工环境) 的天花板、墙与地板、配水管的黑色霉菌, 几乎为该菌或枝孢霉。
5.镰刀菌是一类世界性分布的真菌,它不仅可以在土壤中越冬越夏,还可侵染多种植物(粮食作物、经济作物、药用植物及观赏植物),引起植物的根腐、茎腐、茎基腐、花腐和穗腐等多种病害,寄主植物达100余种。
食用霉变的粮食可导致人患病和死亡。
某些菌种可诱发人皮肤和角膜溃疡。
恶性肿瘤的发生可能与有的菌种有关。
6.根霉黑根霉也称匐枝根霉,分布广泛,常出现于生霉的食品上,瓜果蔬菜等在运输和贮藏中的腐烂及甘薯的软腐都与其有关。
黑根霉(ATCC6227b)是目前发酵工业上常使用的微生物菌种。
黑根霉的最适生长温度约为2~8℃,超过32℃不再生长。
二、霉菌的生长习性与霉菌的生长繁殖关系密切的有水份、温度、基质、通风等条件,为此,只有充分的了解霉菌的生长习性,才能为下一步控制霉菌提供理论依据。
1 水分霉菌生长繁殖主要条件之一是必须保持一定的水分,大部分霉菌于湿度90 %以上, 水含量18 %的高湿度环境下以上容易生长。

食品微生物—霉菌霉菌是一种常见的食品微生物,可以在食品中生长和繁殖,对食品的品质和安全性产生重要影响。
霉菌在食品中的生长和繁殖取决于多种因素,包括温度、湿度、食品成分等。
本文将介绍霉菌的生长特点、对食品的影响以及控制霉菌的方法。
霉菌是一种真菌,具有丝状菌丝,可以在固体或半固体培养基上生长。
霉菌的生长速度比细菌慢,但具有更强的耐受性,可以在广泛的温度和湿度条件下生长。
霉菌可以在食品中繁殖,并产生有毒的代谢产物,如黄曲霉素和伏马菌素等,对人类健康产生潜在威胁。
霉菌在食品中的生长和繁殖会对食品的品质和安全性产生重要影响。
霉菌的生长会改变食品的外观和口感,使其失去原有的营养价值和食用价值。
霉菌会产生有毒的代谢产物,对人体健康产生潜在威胁。
例如,黄曲霉素是一种致癌物质,长期食用含有黄曲霉素的食品会增加患癌症的风险。
霉菌还会导致食品变质和腐败,引发食品安全问题。
为了控制霉菌的生长和繁殖,可以采用以下方法:低温储存:低温可以抑制霉菌的生长和繁殖,因此可以将食品储存在低温下以延长保质期。
干燥:干燥可以降低食品的水分含量,从而抑制霉菌的生长和繁殖。
添加防腐剂:防腐剂可以抑制霉菌的生长和繁殖,从而延长食品的保质期。
紫外线照射:紫外线可以杀死食品中的微生物,包括霉菌。
高压处理:高压可以破坏食品中的微生物细胞壁,从而抑制霉菌的生长和繁殖。
了解霉菌的生长特点和对食品的影响,采取有效的控制方法,有助于保障食品的安全性和品质。
在我们的日常生活中,微生物扮演着各种各样的角色。
它们既可以是人体中的有益菌,帮助我们消化食物,也可以是病原菌,导致各种疾病。
然而,在食品科学领域,微生物则有着更为特殊的地位。
它们不仅影响食品的品质和口感,还可能对人类的健康产生重要影响。
因此,了解食品中的微生物及其作用机理,对于我们合理选择和制备食品具有重要意义。
让我们来了解一下什么是食品微生物。
食品微生物学是一门研究食品中微生物的学科,它涉及到微生物的分类、特性、生长条件、与人类的关系等方面的内容。

食品中常见的微生物在我们日常的饮食中,无论是什么食物,都难免会有某个阶段出现微生物的存在。
这些微生物可能会带来利益,如发酵食品中的益生菌,也可能会带来危害,如肉类中的病原菌。
下面我们就来探讨一下食品中常见的微生物有哪些。
一、细菌细菌是我们日常生活中最常见的微生物,有益菌与有害菌之分。
益生菌可以促进人体肠道菌群的平衡,帮助人体消化吸收食物中的营养成分,维持人体健康;而有害菌则可能引起食物中毒或疾病。
1.厌氧菌:厌氧菌指生长在无氧条件下的细菌,常见的有产气荚膜梭菌和产乳酸梭菌,它们在腐烂的肉类、肠道内常有存在。
这些细菌可以引起人体多种疾病,如伤寒、破伤风等。
2.大肠杆菌:大肠杆菌是一种肠道内常见的细菌,有的亚种对人体有益,有的则可能引起食物中毒。
其中,O157:H7亚型最为恶劣,能够引起严重的细菌性食物中毒,其感染后症状包括恶心、呕吐、腹痛及腹泻等。
3.金黄色葡萄球菌:金黄色葡萄球菌是一种常见的不致病菌,但它也能引起人们平时吃的食品中毒。
它常见于乳制品、蛋糕、肉制品等食品中,如果食品保存不当就可能引起感染。
其感染后的症状包括呕吐、腹泻、发热等。
二、霉菌霉菌是一类单细胞真菌,平时我们买来的柿子、苹果、香蕉等水果,则可能在不同程度上含有霉菌。
一般来说,霉菌对于人体来说是有害的,它们通过分解有机物,产生致癌物质、霉菌毒素等物质。
1.曲霉:曲霉是一种最常见的霉菌之一,它经常生长在发酵的食物上,如腐败的玉米、芝士、豆腐等。
如果食品中含有曲霉毒素且摄入量超过人体承受能力,就有可能引起肝癌。
2.铜绿假单胞菌:铜绿假单胞菌是一种分解蛋白质的菌类,它们常在极少统计中出现,但会导致剧病,以呼吸系统感染、尿路感染、血液感染等最为常见。
3.青霉:青霉常生长在橘子、苹果、柑橘饮料中,在分解产生某些毒性化合物的过程中,对人体健康产生危害。
三、酵母菌酵母菌是单细胞真菌类微生物,常用于制作发酵食品中。
不同于细菌和霉菌,酵母菌一般是有益的,可以产生益生菌以促进消化和健康。
引起食品发霉的霉菌是哪些面包、蛋糕等糕点发生霉变主要是由霉菌作用引起的,其中的污染霉菌种类很多,包括青霉菌、青曲霉、根霉菌、赭霉菌及白霉菌等。
虽然烘焙食品在整个生产过程中,均是使用高温制作,但是烘焙食品的后期保存阶段却易受霉菌等微生物的侵染,从而导致导致食品口味酸败、色泽和营养价值大打折扣,大大降低烘烤食品的保质期。
在潮湿温暖的地方,很多食品上长出一些肉眼可见的绒毛状、絮状或蛛网状的菌落,那就是霉菌。
霉菌是丝状真菌的俗称,意为“发霉的真菌”,它们往往能形成分枝繁茂的菌丝体,而菌丝体常呈白色、褐色、灰色或呈鲜艳的颜色(菌落为白色毛状的是毛霉,绿色的为青霉,黄色的为黄曲霉)。
另外,霉菌也常用孢子的颜色来称呼,如黑霉菌、红霉菌或青霉菌。
烘焙食品中较其他基质的营养丰富,霉菌更容易繁殖,如不加以控制势必会影响烘焙食品的保质期及质量。
因此,只有深入了解霉菌的生长习性,才能更好地控制霉菌的繁殖。
一般霉菌生长繁殖必须保持一定的水份,当烘焙食品水分活度为0.98时,霉菌最易生长繁殖,当水分活度降为0.93以下时,霉菌繁殖受到抑制,但仍能生长,水分活度在0.7以下时,则霉菌的繁殖受到抑制,可以阻止产毒的霉菌繁殖。
另外,环境的温湿度也是很重要品德,不同的霉菌其最适温度是不一样的,多数霉菌繁殖最适宜的温度为25~30℃,在0℃以下或30℃以上,不能产毒或产毒力减弱。
以下为食品中常见的霉菌:毛霉属菌落为絮状,初为白色或灰白色、后味灰色。
毛霉的菌丝多为白色,孢子囊黑色或褐色,孢子囊孢子大部分为无色或浅兰色,因种而异。
一般在高温、高湿及通风不良的条件下生长。
根霉属无定形菌落,初期为白色、老熟后味灰褐色或黑色。
其中的孢子靠气流传播,喜中温,高温偏酸的条件。
曲霉属颜色是曲霉菌分类的重要依据。
烟曲霉菌呈棉花样,开始为白色,2-3日后转为绿色,数日后变为深绿色。
黄曲霉菌呈粉末状,为黄色。
黑曲霉菌呈粉末状,为黑色。
杂色霉菌为绒毛状、羊毛状,从青绿到到红绿。
霉菌的特点及应用霉菌是一类真菌的统称,它们通常以单细胞或多细胞的形式存在。
霉菌具有以下特点:1. 细胞结构:霉菌的细胞由细胞壁、质膜、质网、细胞器等组成,其中质网是细胞内质体的一种特殊形式。
他们具有细长的菌丝和孢子,这些结构有助于霉菌在不同环境中的生存和繁殖。
2. 好氧或厌氧:大部分霉菌属于好氧生物,但也有一些霉菌可以在缺氧环境中生存。
这使得霉菌能够广泛地分布于自然界中的各种环境中,如土壤、水体、空气中等。
3. 营养方式:霉菌属于异养生物,它们无法自主合成有机物质,需要从外界环境中吸收有机物质和无机盐来维持生存。
霉菌通过产生分泌酶来降解有机物质,并通过菌丝吸收分解产物。
4. 产生孢子:霉菌的繁殖主要是通过产生孢子实现的。
孢子是霉菌的生殖体,它们具有抵抗外界环境的能力,可以在各种恶劣条件下存活,如干燥和高温等。
孢子通常以空气中的形式传播,从而完成霉菌的繁殖。
霉菌在生物学、医学、食品工业等方面具有广泛的应用价值:1. 霉菌在食品工业中的应用:一些霉菌具有产酶的能力,可以被用于发酵和制造食品。
比如霉菌可以用来制作奶酪、酸奶、味精等发酵食品,同时也可以用于加速食品的腐败过程。
2. 生物制药领域:某些霉菌可以生产抗生素、激素和维生素等药物,如链霉素、青霉素等。
这些霉菌可以被用于大规模生产药物,为临床治疗提供重要的药物来源。
3. 环境监测:通过检测和监测霉菌的分布和繁殖状况,可以评估环境质量和食品安全。
霉菌的孢子通常存在于空气中,在环境中广泛传播,因此可以通过检测空气中霉菌的数量来评估环境的卫生状况。
4. 生物修复:霉菌在环境修复和废物处理方面也有一定的应用价值。
一些霉菌可以分解和吸附有机和无机污染物,对于清洁环境和废物处理起到积极的作用。
总结起来,霉菌是一类广泛存在于自然界中的真菌,具有多样的营养方式和繁殖方式。
它们在食品工业、生物制药、环境监测和生物修复等领域都有广泛的应用前景。
在科学研究和工业应用中,对于霉菌的研究和利用已成为一个重要的研究方向。